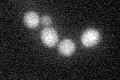
YHR208W
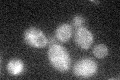
YHR208W

View description
Mitochondrial branched-chain amino acid aminotransferase, homolog of murine ECA39; highly expressed during logarithmic phase and repressed during stationary phase
Localization:
Intensity:
Fold change:
Significance:
-
C’ GFP library in SD
below threshold17.47 -
N' NOP1pr-GFP in SD

mitochondria139.879 -
N' TEF2pr-mCherry in SD

mitochondria268.266 -
N' NATIVEpr-GFP in SD

cytosol242.2 -
N' TEF2pr-VC and Cyto-VN in SD

#N/A0 -
C’ GFP library in SD+DTT

cytosol15.870.9No -
C’ GFP library in SD+H2O2
cytosol19.741.12No -
C’ GFP library in Starvation Media

cytosol25.891.48No -
C’ GFP library on the background of Pup2-DaMP

below threshold -
C’ GFP library on the background of CCT mutant

below threshold16.40780.938729No
